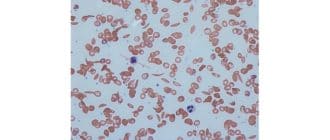

閉塞した卵管が女性の不妊の原因の一つである。通常症状はありませんが、症状を発症する可能性のあるリスク要因があります。閉塞した卵管の医学用語は卵管閉塞である。 卵管は繊細な髪のような構造で裏打ちされた筋肉の管である。これら […]
あなたが初めての保護者であろうと、育児の専門家であろうと、妊娠はしばしば、オンライン妊娠のリソースに依存して100万と1つの質問を投げかけます。妊娠のブログでは、毎週の開発ガイドから個人的な誕生の話まで何かをカバーしてい […]
ヘアケアは非常に個人的な選択です。髪を洗う医学的な理由はほとんどありません。 どのくらいの頻度で髪を洗うかについての決定は、人の髪の種類、頭皮の質感、髪の毛がどのくらいか、個人的な好みによって決まります。 一部の人にとっ […]
中高年に達した成人の予備研究によると、座っている人が多すぎると脳に良くないことがあります。 カリフォルニア大学ロサンゼルス校(UCLA)の研究者らは、認知症のない45-75歳の成人35人のうち、一日のうちにもっと時間を過 […]
鎌状赤血球形質は、赤血球に影響を及ぼす血液疾患である。それは、鎌状赤血球病と同じではありません – 実際、それはまったく病気ではありません。 それは遺伝であることを意味する「形質」です。鎌状赤血球形質(SCT […]
下痢は多くの可能な原因を伴う一般的な状態である。下痢のいくつかの症例は感染によるものである。ときには、それは投薬の副作用として、またはセリアック病および炎症性腸疾患などの他の状態の症状として起こることがある。 この記事で […]
乳癌は主に女性に影響を与える一般的な癌です。乳房切除術は、しばしば皮膚の除去を含む一方または両方の胸部の完全な除去を含む伝統的な治療方法である。 乳房切除術の結果として、女性はしばしば胸に大きな傷跡が残る。肌を節約する乳 […]
目次 線維嚢胞性乳房 線維腺腫 乳房嚢胞 乳がん 乳房塊の徴候や症状は原因によって異なります。この記事では、乳房瘤の原因のいくつか、および発症する可能性のある特定の徴候および症状について検討します。 乳房の塊を感じる人は […]
正しい姿勢をとることは、良い姿勢と健康的な背中と背骨を維持する上で不可欠です。ほとんどの人は、いくつかの簡単なガイドラインに従って、座っている姿勢を改善することができます。 まっすぐ背中と肩に座ると、人の健康を改善するだ […]
セックス中毒は、多くのテレビ番組や雑誌や映画の笑いの基礎ではありますが、現実には、セックス中毒は家族や関係、人生を破壊する条件です。 しかし、精神科医は、このトピックに関する研究が不足しているため、「管理外の性行為」が精 […]
利尿剤は、余分な体液や塩分を取り除くために使用されます。高血圧、心不全、腫脹した組織、および腎臓疾患を有する人々は、これらの状態を治療するために利尿剤を使用することが多い。 体内の余分な体液は、心臓が適切に機能するのを困 […]
乳頭腫は、良性で外向きに発生する塊であり、一部の場所で問題を引き起こす可能性があります。乳頭腫は広がりません。彼らは攻撃的でも癌性でもありません。 しかし、医師が見た塊や皮膚の病変を得ることは重要です。これは良性で、心配 […]
電解質、ビタミン、ミネラルの濃度で知られているココナッツウォーターは、国を席巻しています。ヨガスタジオから自動販売機にいたるまで、どこでも熱帯飲料を購入できます。 ココナッツの水は、緑色のココナッツの透明な液体から作 […]
血液銀行は、輸血に使用するための標準的な輸血期限であることを6週間と考えている。現在、米国の新しい小規模な研究では、このタイムスケールを3週間に短縮する必要があることが示唆されている証拠が増えている。なぜなら、保存血液中 […]
身長の低い人、または成長が制限されている人は、同じ性別、年齢、人種の他の人よりも高く成長しません。人の身長は3パーセンタイル未満です。 短い身長は、正常な成長の変種であり得るか、または障害または状態を示し得る。 成長率は […]
フォード斑点は、陰茎、陰唇、陰嚢の軸、または唇の隣に現れる小さな隆起した隆起である。彼らは薄い赤、黄色、または肌色にすることができます。 彼らはまたフォード顆粒や皮脂分画として知られています。彼らは男性と女性の両方に共通 […]
アーモンドミルクは、米国で最も人気のある植物ミルクです。 それはいくつかの健康的な栄養素が豊富ですが、全体のアーモンドと比較して、それは水分が少なく、繊維のほとんどが欠けています。 健康影響は管理された研究で直接検査され […]
クレアチンは体内の細胞、特に筋細胞にエネルギーを供給するのに役立つ窒素有機酸です。 それは赤身と魚に自然に発生し、体によって作られ、サプリメントからも得られます。 サプリメントは、運動能力の向上、高齢者による筋肉量の増加 […]
毛細血管拡張症は、皮膚または粘膜の表面近くに見られる、小さくて、壊れた、または広がった血管である。 彼らは通常、細かいピンクまたは赤の線として表示され、圧力の下で白くなります。毛細血管拡張症が皮膚に現れると、細い線は赤か […]
シーバー病は、身体活動的な子供に生じるかかとの損傷である。一時的な痛みを引き起こしますが、長期間の傷害を引き起こさない一般的な苦情です。 シーバー病は、1912年に最初にこの状態を記述したアメリカの医師であるジェームズ・ […]
Seve Ballesterosは、脳腫瘍との長い戦いの後、今日の早い時間に死亡した。彼の家族は、昨日の夜、彼の神経学的状態が「重度の悪化を経験した」ことを説明するコミュニケを発行した。バレステロスは1970年代半ばから […]